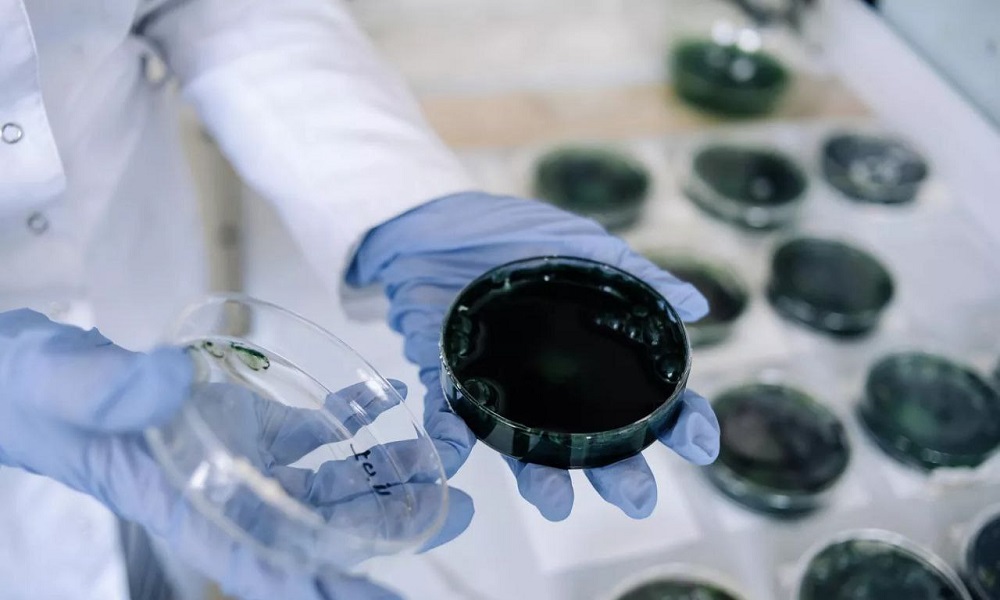
Учёные ОмГТУ представили новую разработку — полезные сладости, состав которых усилен белком и железом

Учёные ОмГТУ представили новую разработку — полезные сладости, состав которых усилен белком и железом
Сладости и снеки обогащены сибирской водорослью.
Научные сотрудники Омского государственного технического университета презентовали новую серию полезных десертов и снеков, насыщенных белком и железом, благодаря использованию уникальной сибирской водоросли. Сегодня активно развиваются технологии обогащения повседневных продуктов необходимыми организму веществами. Специалисты ОмГТУ решили внести вклад в развитие функционального питания, создав специальную линию здоровых продуктов. В неё входят различные виды мармеладных конфет, пастилы, маршмеллоу и снеков. Особенность новинок состоит в присутствии в рецептуре местного сорта сине-зелёных водорослей, известных как спирулина. Как подчеркнули авторы разработки, включение в состав спирулины обеспечивает существенное повышение уровня полезности продукта без ухудшения вкуса. Профессор кафедры биотехнологии ОмГТУ Елена Молибога пояснила, что традиционная пастила практически не содержит белков, тогда как их версия богата питательным веществом — до 80%. Кроме того, команда исследователей организовала полный цикл производства продуктов, начиная с собственного разведения местной спирулины в лабораторных условиях и заканчивая созданием готовых изделий путём специальной обработки методом сублимационной сушки.
Таким образом, омские специалисты предлагают потребителям не только удовольствие от любимых сладостей, но и возможность компенсировать недостаток важных микроэлементов натуральным способом, отказавшись от синтетических витаминных добавок. Исследователи отмечают, что на сегодняшний день они завершили разработку технологического регламента и определили оптимальные пропорции ингредиентов, обеспечивающих высокое качество и пользу новых перекусов.
Фото: пресс-служба ОмГТУ.
По теме:
Омские учёные разработали полезный мармелад для диабетиковТри выпускницы омского политеха создают безалкогольное пиво с помощью математического моделирования
Теги
Поделиться новостью
Новости партнеров
По теме

